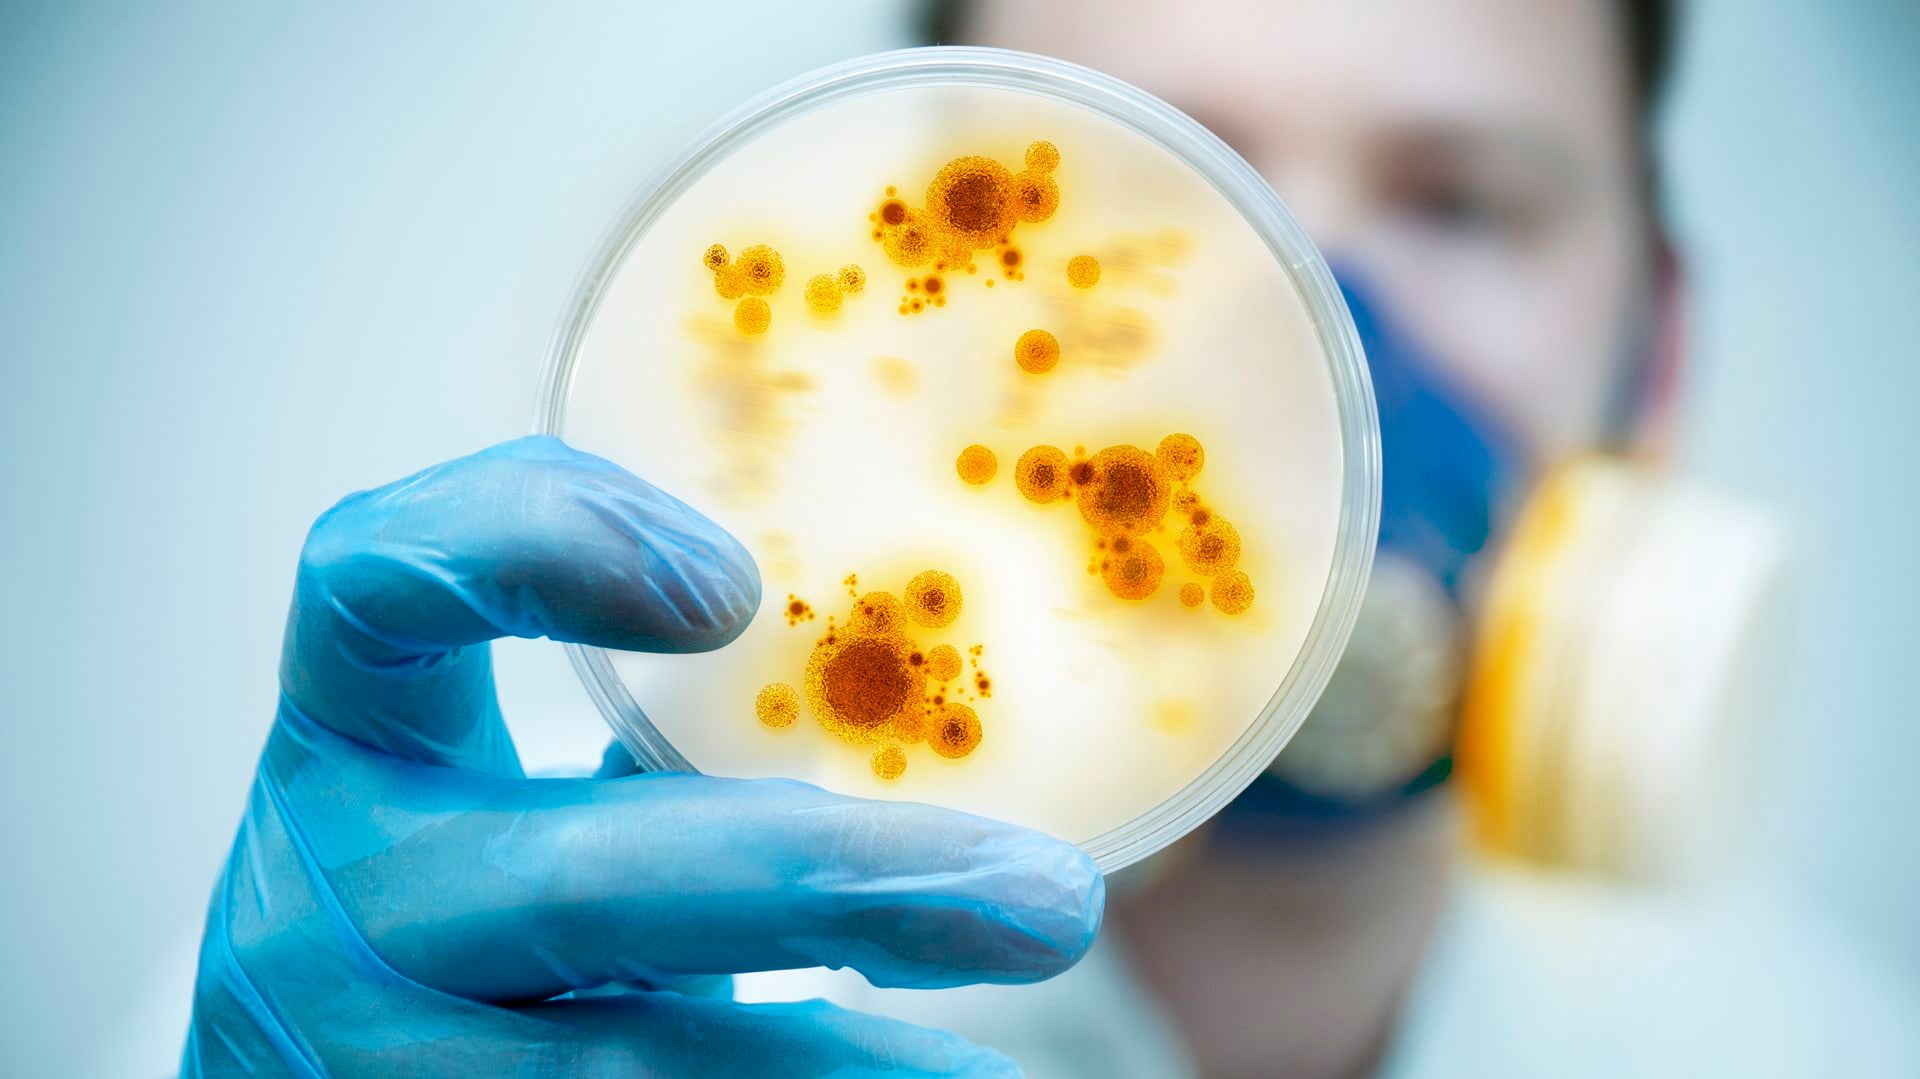

La modelo Silvina Luna está internada grave y en los últimos días se contagió COVID. Qué reveló un estudio en América Latina y cuáles son las recomendaciones de expertos consultados por Infobae
Los hospitales se han construido para dar cuidados y tratamientos a las personas con diferentes problemas de salud. Pero los pacientes también pueden correr riesgos de contraer infecciones que no tenían antes de ser internados.
:quality(85)/cloudfront-us-east-1.images.arcpublishing.com/infobae/3P4QZD7ID5DMBDJS2QJ2JT7CVI.jpg)
Te puede interesar:Los casos de COVID crecieron un 63%: qué se sabe sobre Pirola, la nueva subvariante de Ómicron
El nivel de riesgo no necesariamente siempre es alto si se toman medidas que están comprobadas científicamente para lograr la prevención.
Días atrás, la actriz y modelo argentina, Silvina Luna, adquirió el coronavirus mientras se encuentra hospitalizada por insuficiencia renal y otros problemas de salud.

En 2010, otro caso había llamado la atención cuando Sandro, el cantante conocido por su canción “Rosa Rosa”, había recibido un trasplante y luego adquirió una infección por la bacteria Acinobacter baumannii dentro de una institución hospitalaria.
Te puede interesar:Estudian si los lobos marinos muertos en Necochea tenían gripe aviar, tras detectarse 8 casos en la Patagonia
Son bacterias, virus u hongos que se transmiten dentro de los hospitales y causan lo que hoy se conoce como “infecciones asociadas al cuidado de la salud”.
Un equipo de investigadores que trabajan en los Estados Unidos, Costa Rica, Colombia, México, Panamá y Brasil analizó cuáles son los factores que aumentan el riesgo de morir dentro de los hospitales en América Latina y su estudio fue publicado en la revista Journal of Epidemiology and Global Health.

“Antes de realizar el estudio, habíamos hecho otra investigación por la cual encontramos que la tasa promedio de mortalidad en hospitales de América Latina solo alcanza al 17% de los pacientes internados si no adquieren una infección hospitalaria”, contó a Infobae el médico argentino Víctor Rosenthal, fundador y presidente de la Comunidad Científica Internacional de Control de Infecciones Nosocomiales y el primer autor del estudio.
“En cambio, cuando un paciente hospitalizado adquiere una infección, la tasa de mortalidad es del 30%. Cuando tienen dos infecciones, sube al 40%. Si el paciente adquiere tres infecciones, la mortalidad puede llegar al 63 %”, agregó.
Te puede interesar:Un brote de triquinosis afectó a 118 personas de 9 municipios bonaerenses
El equipo científico hizo un estudio prospectivo en 198 unidades de terapia intensiva de 96 hospitales en 12 países latinoamericanos. Incluyeron a más de 71.000 pacientes que estuvieron en terapia intensiva entre 1998 y 2022. En conjunto, estuvieron hospitalizados más de 652.000 días.
Qué factores aumentan el riesgo de mortalidad en hospitales

Durante el período estudiado, 4.700 pacientes adquirieron infecciones en los hospitales y 10.890 fallecieron. Tras el análisis de los datos, los investigadores señalaron que algunos de los factores de riesgo de mortalidad en los hospitales son el nivel socioeconómico del país, el tipo de hospital (público, privado o de organizaciones sin fines de lucro), el tipo de hospitalización, el tipo de unidad de terapia intensiva y la edad de cada paciente.
Hay también otros factores que son más fáciles de modificar, según los autores. “En base a nuestro estudio -explicó Rosenthal- detectamos que la tasa de infecciones en hospitales es un factor que puede contribuir a la mortalidad, pero que puede ser cambiado. Por eso, deberían hacerse esfuerzos para reducir los días de uso del catéter venoso central o sondas vesical, y el respirador mecánico en los pacientes”.
También hay oportunidades para reducir las tasas de neumonía asociadas al uso de respirador o la de infección urinaria asociada al uso de catéter. Es decir, más allá de que en los países en desarrollo los pacientes tengan más chances de padecer una infección hospitalaria, mucho se puede hacer. No es una situación inexorable.
“Al estar internado en el hospital o al tener un familiar internado, no solo hay que preocuparse por el lavado frecuente de manos sino que también hay que tener en cuenta que el uso de dispositivos aumenta el riesgo de adquirir infecciones dentro del hospital”, expresó el especialista.

El uso de cada uno de los dispositivos aumenta la mortalidad en 3 y 4% por cada día que el paciente los usa. “El resultado de nuestro estudio no significa que no haya que usar los dispositivos. El mensaje es que hay que evaluar profundamente en qué caso se requiere su utilización y cuánto tiempo es necesario”, aclaró Rosenthal.
Además, resaltó que “hay medidas específicas para el manejo de los dispositivos que previenen que los pacientes adquieran una infección hospitalaria”.
Hay diferencias en cuanto a las tasas de infecciones de los pacientes internados en terapia intensiva. En Chile, Brasil, Uruguay, y Colombia, la tasa es menor al 5%. En cambio, en la Argentina la tasa de infecciones en terapia intensiva ha llegado a estar en 32% según el programa del Ministerio de Salud de la Nación en 2017. En los Estados Unidos, esa tasa es del 2%.

Otro estudio -publicado en 2020 por Cambridge University Press– fue realizado por las médicas investigadoras Wanda Cornistein, Cristina Freuler y María Inés Staneloni, entre otras. Allí se comparó las diferencias entre las tasas de los hospitales que hacen esa notificación voluntaria y las de tres instituciones privadas que tienen la certificación de la Joint Commission International.
“Desde el momento de nuestra publicación hubo avances en la generación de comités de control de infecciones en hospitales que reportan de manera voluntaria. Es un camino que se ha iniciado y es importante que se sostengan y optimicen los programas de prevención de infecciones en todas las instituciones de nuestro país”, expresó Staneloni, al ser consultada por Infobae.
Se ha demostrado que los programas de control de infecciones pueden bajar las infecciones hospitalarias en un 60% y la resistencia a los antimicrobianos cuando se combinan con programas de optimización del uso de antimicrobianos en un 66%, señaló la especialista, quien es co-fundadora de la asociación Investigación de la Resistencia Antimicrobiana (INVERA).
Cómo prevenir las infecciones hospitalarias
Las infecciones hospitalarias no son solo un asunto que involucre a los profesionales de la salud. También pacientes, familiares y la comunidad en general pueden hacer mucho por la prevención como parte del derecho humano a la salud.
De acuerdo con Staneloni, “los pacientes pueden ser parte de los programas de control de infecciones como las campañas de higiene de manos. Pueden promover que el personal que los asiste se lave las manos”.
También las personas pueden consultar si existen programas de control de infecciones en los hospitales cercanos. “Es parte de la salud y es un derecho de todos”, afirmó.

Los Centros para el Control y la Prevención de Enfermedades (CDC) de los Estados Unidos también han brindado estas recomendaciones para protegerse:
– Se debe informar a los médicos si se ha estado hospitalizado en otro centro dentro o fuera del país o si ha sufrido recientemente una infección.
– Pregunte qué harán dentro del centro hospitalaria como protección contra una infección resistente a los antibióticos.
– Si un paciente tiene un catéter, puede preguntar a diario cuándo se lo pueden retirar.
– Si lo van a operar, puede preguntar cómo se hará prevención de las infecciones y cómo se puede preparar para la operación para reducir el riesgo.
– Permita que limpien la habitación mientras esté en el hospital, aunque le resulte incómodo
INFOBAE